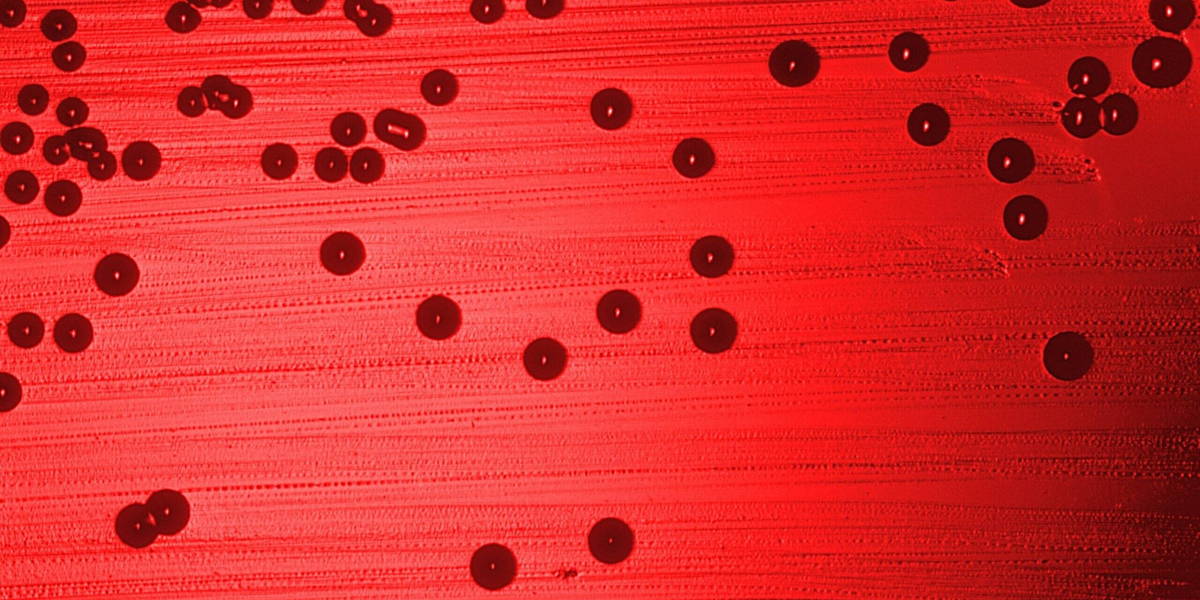
Haemophilus_influenzae_011-scaled

Voor het eerst is bij een hemofiliepatiënt in Nederland succes geboekt met gentherapie. De patiënt is niet genezen, maar de ziekte is daardoor voorlopig teruggebracht van een ernstige naar een milde vorm.
Dat maakt een enorm verschil: in plaats van twee keer per week een bloedtransfusie met stollingsfactor IX is er slechts in uitzonderlijke situaties een transfusie nodig. Bovendien heeft de patiënt vrijwel geen gewrichtsbloedingen meer, waardoor de gewrichten niet langer door de hemofilie zullen verslijten. Het is afwachten of het effect lang aanwezig blijft; de onderzoekers zijn voorzichtig optimistisch.Succesvolle gentherapie bij hemofiliepatiënt AMC
Ook dit onderwerp krijgt een prominente plek tijdens de ICT&health World Conference 2027. Wil je erbij zijn en niets missen? Reserveer dan tijdig je ticket.









